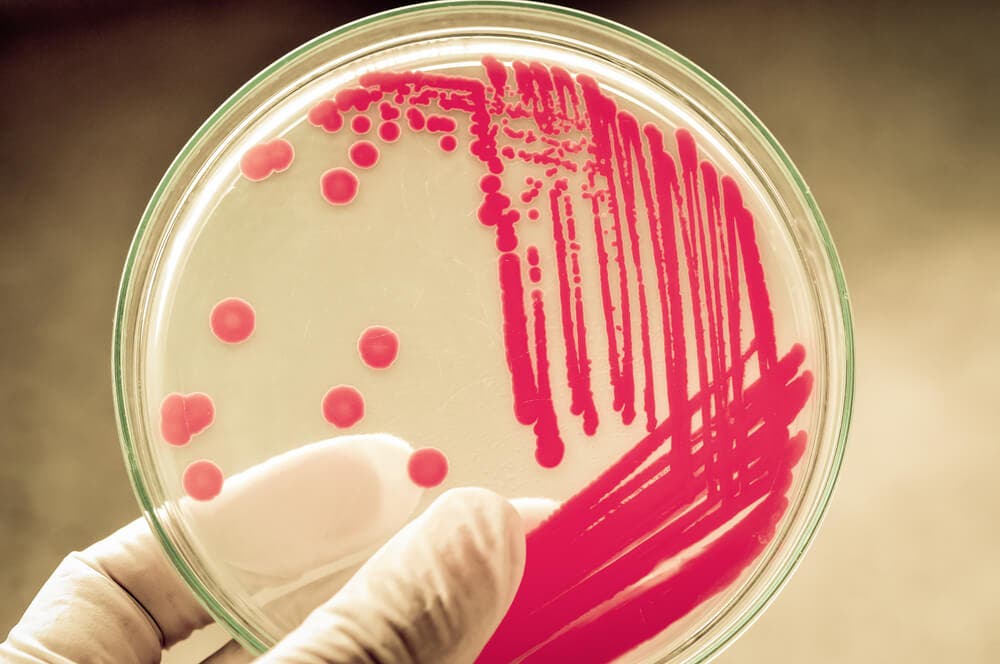

Vancomicina: indicaciones, mecanismo y reacciones adversas


Revisado y aprobado por el biotecnólogo Alejandro Duarte
La vancomicina es un antibiótico glucopeptídico indicado en el tratamiento de segunda elección en pacientes que son alérgicos a la penicilina o a los β-lactámicos.
En un antibiótico natural derivado de la bacteria gram + Nocardia orientalis eficaz frente a bacterias gram +, aerobias y anaerobias. Su uso está totalmente contraindicado en aquellos pacientes con antecedentes o historial de reacciones alérgicas a este medicamento.
¿Bacteria gram + o gram-?
Dependiendo de la estructura de la pared celular de las bacterias, las podemos clasificar en gram + y en gram –. Las primeras presentan una membrana celular compuesta por péptidoglucano y una membrana citoplasmática interna formada por una doble capa de lípidos.
Por otro lado, las gram -, que además de la membrana interna citoplasmáticas, tienen otra bicapa de lípidos en la membrana más externa. Entre ambas membranas hay un espacio que se denomina espacio periplasmático.
Este espacio de las bacterias gram – está formado por péptidoglucano, que es mucho más grande y ancho que en las bacterias gram +. Como podemos observar, la membrana celular de las gram – es más compleja que la de las de signo opuesto.
Para saber si se trata de un tipo u otro, se deben realizar una serie de pruebas en el laboratorio que nos permiten clasificar a las bacterias. La técnica más conocida es la tinción de Gram.
Mecanismo de acción de la vancomicina
La vancomicina debe su efecto a la capacidad que presenta de inhibir la síntesis de la pared celular de las bacterias gram + desde fuera, es decir, no necesita penetrar en la célula para desarrollar su acción.
Es un antibiótico bactericida, lo que quiere decir que provoca la muerte directa del microorganismo, a diferencia de los bacteriostáticos, que lo que hacen es inhibir el crecimiento, sin inducir la muerte.
La pared celular bacteriana es un elemento de las células de las bacterias imprescindible para la vida de estos microorganismos.
Es eficaz frente infecciones de bacterias anaerobias (son las que pueden vivir en ausencia de oxígeno) y aerobias (requieren oxígeno para vivir). Cuando se administra en una infección provocada por una bacteria gram -, va a disminuir el entramado del peptidoglicano, favoreciendo la acción de los antibióticos específicos de estas bacterias.
Es por ello por lo que se utiliza mucho en el ámbito hospitalario en asociación con antibióticos activos frente a infecciones de gram – como son los aminoglucósidos.
Farmacocinética
Normalmente la vancomicina se administra por vía intravenosa. Sin embargo, en ciertas circunstancias, como por ejemplo en el tratamiento de la colitis pseudomembranosa, se utiliza por vía oral. Las concentraciones máximas en sangre se suelen observar en sangre a las dos horas de la administración intravenosa.
Es un fármaco que se une aproximadamente en un 55% a proteínas plasmáticas en pacientes sanos. Si la persona sufre alguna infección, este grado de unión disminuye hasta aproximadamente un 30-40%, dependiendo del grado de disfunción renal y del grado de hipoalbuminemia ( concentración baja de albúmina, que es la principal proteína del plasma).
La vancomicina se excreta por filtración glomerular en el riñón sin metabolizar. No obstante, cuando se administra por vía oral, la mayor parte de este antibiótico se elimina por las heces.
Lee también: Cómo recuperar la microbiota si consumes antibióticos
Reacciones adversas de la vancomicina
Es un fármaco que presenta una elevada toxicidad, siendo la ototoxicidad y la nefrotoxicidad los dos efectos adversos más graves. La ototoxicidad de la vancomicina se puede manifestar a través de una toxicidad coclear (tinnitus) o toxicidad vestibular, que abarca síntomas como ataxia, vértigo, náuseas y vómitos.
Se cree que esta ototoxicidad es debida a una administración de una dosis elevada, a una exposición prolongada al fármaco, al uso concominantes de otros fármacos ototóxicos, al ruido excesivo, a la deshidratación y a la bacteremia, que es la presencia de las bacterias en sangre.
En cuanto a la nefrotoxicidad, esta suele aparecer en casos raros. La posibilidad de padecer este efecto adverso disminuye cuando las concentraciones plasmáticas de vancomicina están por debajo de los 10mg/ml.

Sin embargo, los efectos nefrotóxicos pueden ser aditivos si se administra conjuntamente con otros fármacos que también presenten estas características. Hemos visto que una asociación muy típica es la de administrar este fármaco con los aminoglucósidos. En esta situación, la probabilidad de sufrir nefrotoxicidad aumenta mucho, ya que los aminoglucósidos son un tipo de antibiótico que presentan mucha toxicidad en estos órganos.
Lee también: Antibióticos: ¿por qué no se puede abusar de ellos?
Síndrome del cuello rojo
Este síndrome es una reacción adversa característica de este antibiótico. Se produce cuando se ha llevado a cabo una infusión intravenosa rápida de vancomicina. Esto hace que se libere histamina en el organismo. La histamina es la molécula responsable de producir las reacciones anafilácticas que se caracterizan por:
- Fiebre
- Escalofríos
- Taquicardia
- Sofocos
- Prurito
Además de estos síntomas, produce un enrojecimiento en la cara, cuello y en la parte superior del tronco del paciente. Esta reacción anafiláctica, que engloba todos los síntomas anteriores, se denomina ”Síndrome del hombre rojo”.
Todas las fuentes citadas fueron revisadas a profundidad por nuestro equipo, para asegurar su calidad, confiabilidad, vigencia y validez. La bibliografía de este artículo fue considerada confiable y de precisión académica o científica.
- Levine, D. P. (2006). Vancomycin: A History. Clinical Infectious Diseases. https://doi.org/10.1086/491709
- Bauer, L. (2008). Vancomycin. Applied Clinical Pharmacokinetics. https://doi.org/10.1036/0071476288
- Cetinkaya, Y., Falk, P., & Mayhall, C. G. (2000). Vancomycin-resistant enterococci. Clinical Microbiology Reviews. https://doi.org/10.1128/CMR.13.4.686-707.2000
- Soju, C., Dawn, M. S., Jeffrey, C. H., Matthew, L. B., Fred, C. T., Frances, Pouch, D., … Scott, K. F. (2003). Infection with Vancomycin-Resistant. The New England Journal of Medicine. https://doi.org/10.1128/CDLI.10.4.564
Este texto se ofrece únicamente con propósitos informativos y no reemplaza la consulta con un profesional. Ante dudas, consulta a tu especialista.







